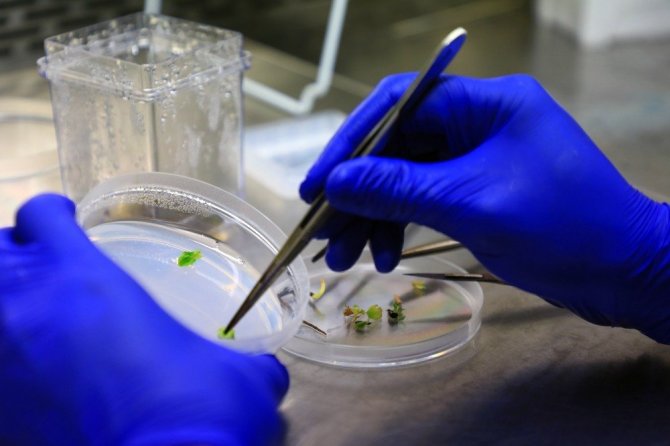

Gökova susamı gelecek nesimler için donduruldu
Muğla Büyükşehir Belediyesi'nin "Yerel Tohum Ulusal Güç" sloganı ile kurduğu ve Türkiye'nin en kapsamlı yerel tohum merkezi olan Tıbbi Aromatik Bitkiler...
Muğla Büyükşehir Belediyesi'nin "Yerel Tohum Ulusal Güç" sloganı ile kurduğu ve Türkiye'nin en kapsamlı yerel tohum merkezi olan Tıbbi Aromatik Bitkiler ve Yerel Tohum Merkezi ata tohumlarının toplandığı bir merkez olarak hizmet vermeye devam ediyor.
Meydana gelebilecek salgın, doğal afet, kıtlık gibi durumlarda yerel tohumların güvenle saklanarak gelecek nesillere aktarılması ve üretiminin sağlanması amacıyla Tohum merkezinde kurulan özel laboratuvarda donduruluyor.
Özellikle Muğla simidi, tahin ve helva yapımında kullanılan ve Türkiye'de susam üretiminde 3. Olan Muğla'da "Gökova Susamı" dondurularak gelecek nesillere aktarılıyor.
Gökova Susamı Kitapçığı Hazırlandı
Doç. Dr. Ergun Kaya ve teknik ekibi ile Muğla Büyükşehir Belediyesi tarafından
yerel tohumların korunması ve kriyoprezervasyon tekniği ile saklanarak gelecek nesillere aktarılması ile ilgili kitapçık hazırlandı. Gökova Susamının Biyoteknolojik Yöntemlerle Çoğaltımı ve Kriyojenik yöntemlere Koruma altına alınmasının konu edildiği kitapçıkta ayrıca Gökova susamının özellikleri ve bu teknik ile saklanan ilk yerel tohumlardan olduğu anlatıldı. Kitapçık büyükşehir belediyesi halka dağıtılarak yerel tohumların saklanma yöntemleri ile ilgili bilgi sahibi olmaları amaçlanıyor.

Türkçe karakter kullanılmayan ve büyük harflerle yazılmış yorumlar onaylanmamaktadır.